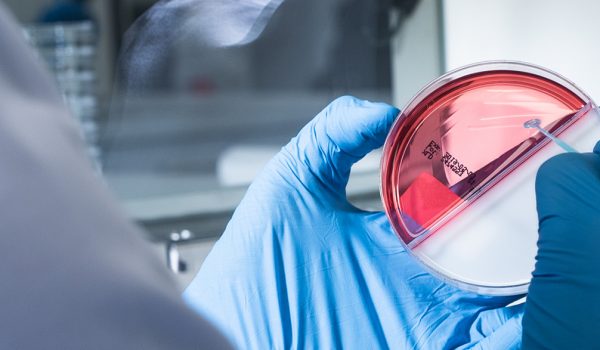

Services
We provide a wide range of Services
Your full-service lab for Agricultural product. Our mission is to ensure the generation of accurate.
Services
We offer state-of-the-art laboratory testing for Food & Feed, Nutraceutical & Supplement, Agriculture & Environment, and Agrosciences, using physio-chemical, instrumental, microbiological, molecular biological, sensorial and mechanical methods through an international network of laboratory and office locations following our customers and the chain of custody.
Microbiology Lab
We take a solution-oriented and flexible approach to the sensory, instrumental, physio-chemical and microbiological analysis of your goods when it comes to quality, ingredients, sanitation, pollution or regulatory compliance. We guarantee you the highest safety and expertise through the latest technical equipment and highly qualified, continuously trained staff. The reliability of our analyses is regularly verified by successful proficiency tests. Numerous references are evidence of the satisfaction and loyalty of our customers.

Chemistry Lab
We take a solution-oriented and flexible approach to the sensory, instrumental, physio-chemical and microbiological analysis of your goods when it comes to quality, ingredients, sanitation, pollution or regulatory compliance. We guarantee you the highest safety and expertise through the latest technical equipment and highly qualified, continuously trained staff. The reliability of our analyses is regularly verified by successful proficiency tests. Numerous references are evidence of the satisfaction and loyalty of our customers.
Product Inspection
We take a solution-oriented and flexible approach to the sensory, instrumental, physio-chemical and microbiological analysis of your goods when it comes to quality, ingredients, sanitation, pollution or regulatory compliance. We guarantee you the highest safety and expertise through the latest technical equipment and highly qualified, continuously trained staff. The reliability of our analyses is regularly verified by successful proficiency tests. Numerous references are evidence of the satisfaction and loyalty of our customers.


Product Certification
We take a solution-oriented and flexible approach to the sensory, instrumental, physio-chemical and microbiological analysis of your goods when it comes to quality, ingredients, sanitation, pollution or regulatory compliance. We guarantee you the highest safety and expertise through the latest technical equipment and highly qualified, continuously trained staff. The reliability of our analyses is regularly verified by successful proficiency tests. Numerous references are evidence of the satisfaction and loyalty of our customers.
Shelf-Life and Stability Study
We take a solution-oriented and flexible approach to the sensory, instrumental, physio-chemical and microbiological analysis of your goods when it comes to quality, ingredients, sanitation, pollution or regulatory compliance. We guarantee you the highest safety and expertise through the latest technical equipment and highly qualified, continuously trained staff. The reliability of our analyses is regularly verified by successful proficiency tests. Numerous references are evidence of the satisfaction and loyalty of our customers.


Training
We take a solution-oriented and flexible approach to the sensory, instrumental, physio-chemical and microbiological analysis of your goods when it comes to quality, ingredients, sanitation, pollution or regulatory compliance. We guarantee you the highest safety and expertise through the latest technical equipment and highly qualified, continuously trained staff. The reliability of our analyses is regularly verified by successful proficiency tests. Numerous references are evidence of the satisfaction and loyalty of our customers.